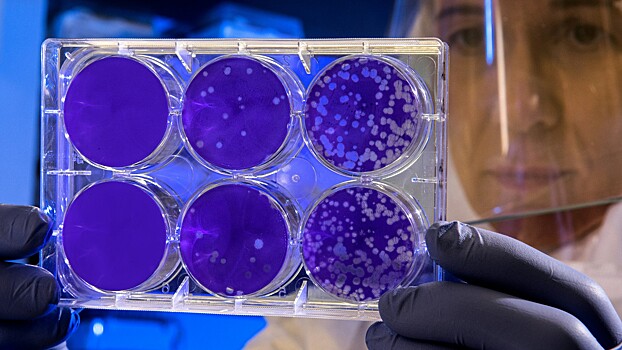
ИИ помог выявить устойчивых к антибиотикам бактерий

Ученые из Университета Цюриха разработали искусственный интеллект (ИИ), способный выявлять бактерии, устойчивые к антибиотикам. Команда под руководством профессора Адриана Эгли из Института медицинской микробиологии первой исследовала, как модель GPT-4 может помочь в анализе антибиотикорезистентности.
Учёные применили ИИ для интерпретации теста Кирби-Бауэра, который помогает врачам определить, какие антибиотики могут бороться с определенной бактериальной инфекцией. На основе GPT-4 был создан инструмент «EUCAST-GPT-expert», который следует строгим рекомендациям Европейского комитета по испытанию антимикробной чувствительности. Система была протестирована на сотнях бактериальных изолятов, что позволило выявить резистентность к жизнеобеспечивающим антибиотикам.
Хотя система показала хорошие результаты в выявлении определенных типов резистентности, она не была безошибочной. Искусственный интеллект иногда ошибочно определял бактерии как резистентные, что могло приводить к задержкам в лечении. Однако система может помочь стандартизировать и ускорить диагностический процесс.
Эгли подчеркивает, что необходимы дополнительные тестирования и усовершенствования, прежде чем этот инструмент можно будет использовать в больницах. Несмотря на ограничения, исследование подчеркивает трансформационный потенциал ИИ в здравоохранении и его способность улучшить диагностику антибиотикорезистентных инфекций.
